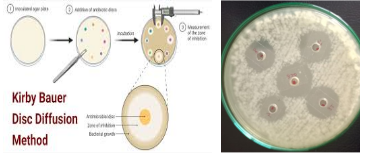

Deskripsi:
Pengujian Sensitivitas Antimikroba adalah pemeriksaan mikrobiologi yang bertujuan untuk mengetahui tingkat kepekaan (sensitivitas) suatu bakteri terhadap berbagai jenis antibiotik atau senyawa antimikroba. Pemeriksaan ini sangat penting untuk mendukung terapi yang tepat, mencegah resistensi antibiotik, serta mengarahkan penggunaan antimikroba yang rasional.
Metode yang umum digunakan antara lain adalah Kirby-Bauer disk diffusion, E-test, dan MIC (Minimum Inhibitory Concentration). Hasil uji ini akan menunjukkan apakah suatu bakteri tergolong sensitif, intermediate, atau resisten terhadap antimikroba tertentu, sesuai standar dari CLSI atau EUCAST.
Jenis Aplikasi yang Bisa Digunakan:
- Klinis dan Rumah Sakit: Menentukan terapi antibiotik yang paling efektif bagi pasien berdasarkan uji kultur dan resistensi.
- Riset Farmasi dan Medis: Mengembangkan dan mengevaluasi efektivitas antibiotik atau senyawa antimikroba baru.
- Industri Obat Tradisional dan Herbal: Uji efektivitas bahan aktif terhadap mikroorganisme patogen.
- Monitoring Resistensi Antimikroba: Menyediakan data penting untuk surveilans resistensi di masyarakat dan fasilitas kesehatan.
- Pendidikan dan Penelitian Akademik: Mendukung praktikum dan riset terkait mikrobiologi klinis dan farmasi.
Jenis Sampel:
- Isolat bakteri dari pasien (darah, urin, sputum, luka, feses, dll.)
- Isolat mikroba dari lingkungan rumah sakit atau alat medis
- Isolat dari bahan makanan, air, atau lingkungan
- Senyawa antimikroba uji (antibiotik standar, ekstrak tanaman, disinfektan)
- Kultur murni hasil isolasi dari penelitian
Biaya : Rp. 200.000/sampel